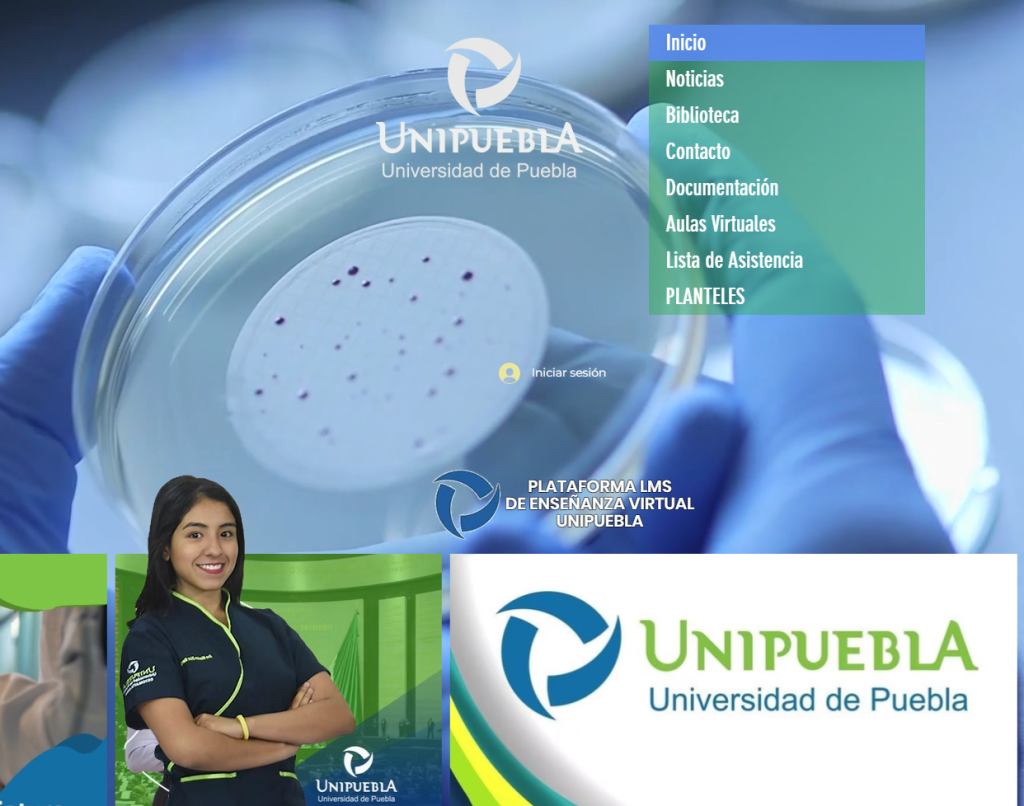

Plataformas IES
En IES Universidad tenemos para ti, estudiante universitario, nuestras Plataformas Educativas con herramientas de vanguardia para que tu educación sea más fácil y práctica.




En IES Universidad tenemos para ti, estudiante universitario, nuestras Plataformas Educativas con herramientas de vanguardia para que tu educación sea más fácil y práctica.